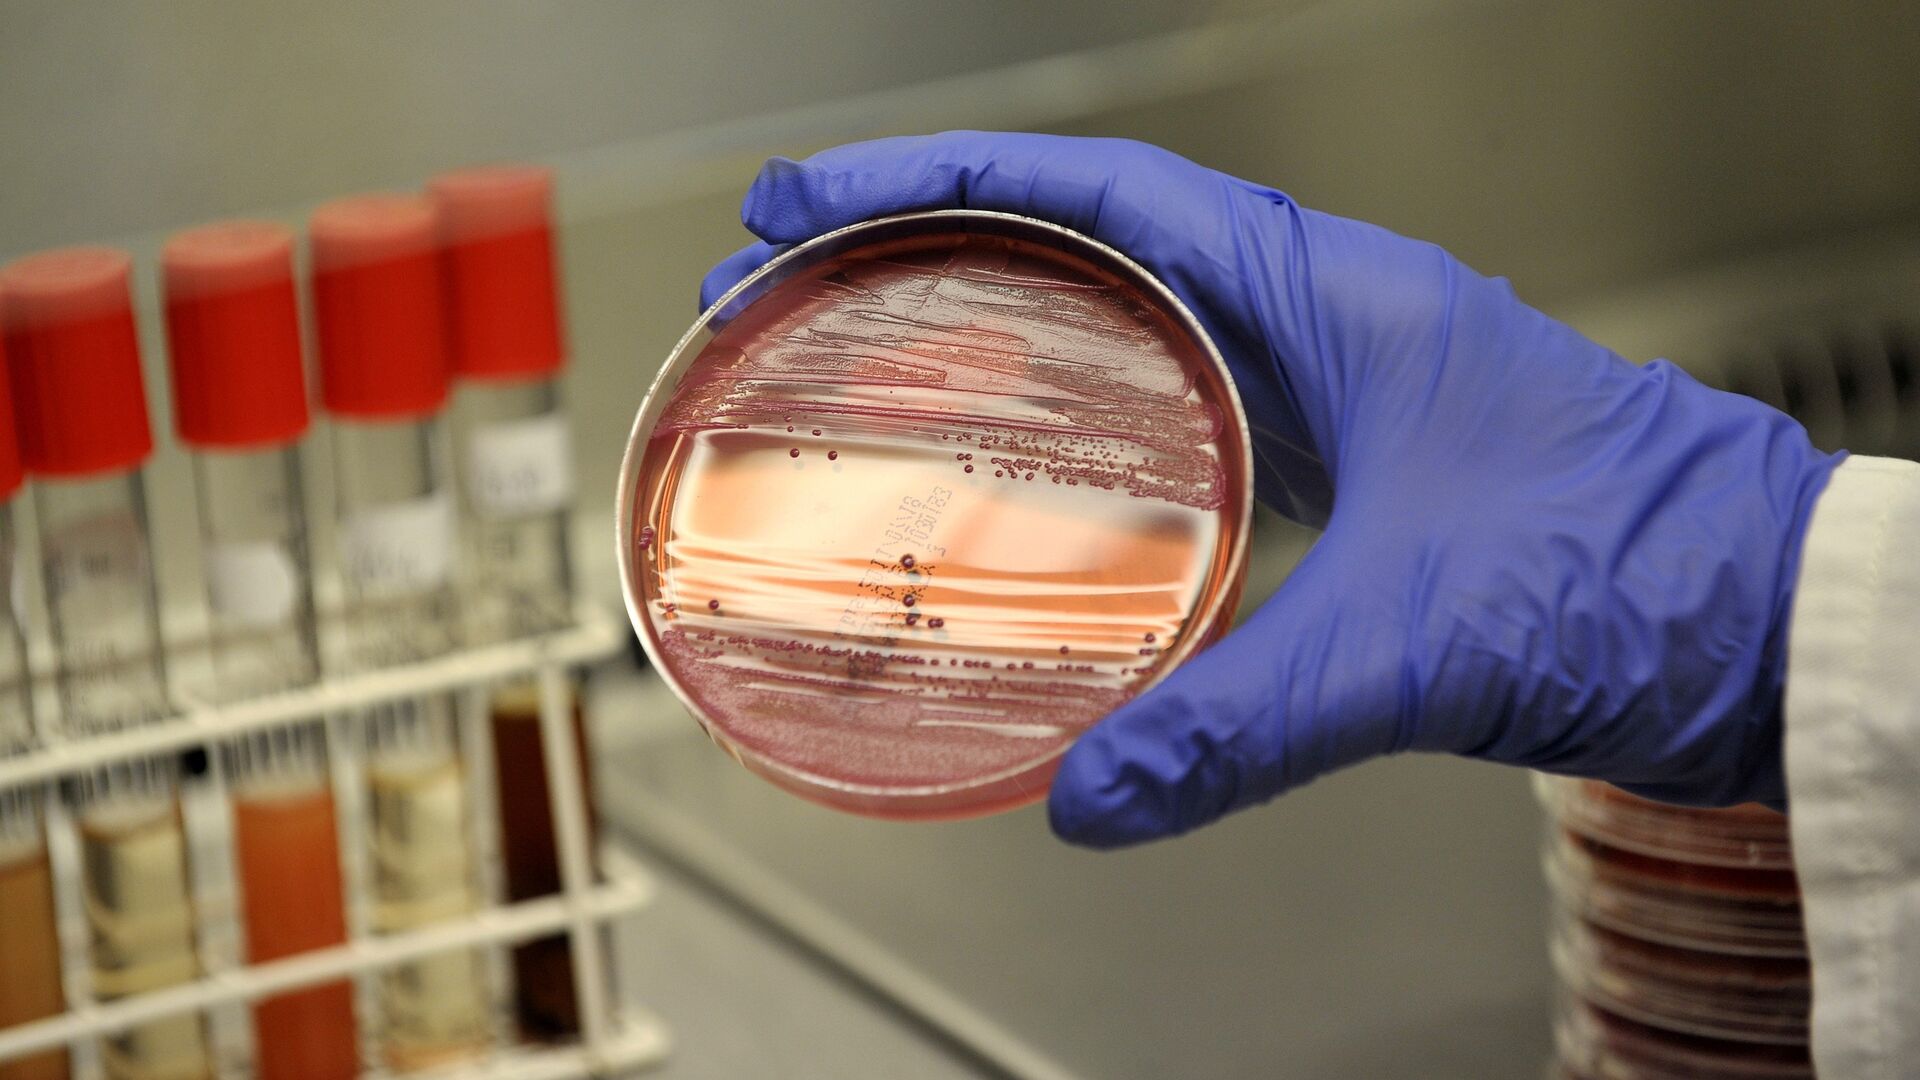
Бактерии кишечной инфекции - РИА Новости, 1920, 23.12.2025

МОСКВА, 23 дек - РИА Новости. Недоверие к вакцинации проявляется во всем мире, но в РФ охваты высокие, дети и взрослые защищены достаточно хорошо, заявила глава Роспотребнадзора Анна Попова.
"Пандемия, скорее инфодемия этого периода внесла свои не самые позитивные изменения в настроение в мире в целом. Во-первых, определенное недоверие к вакцинации проявляется, а во-вторых, те пропуски вакцинации, которые были в период пандемии в самом разном количестве, в разных странах, в большом их количестве, они, конечно, сегодня и демонстрируют результаты. Количество людей, которые не имеют иммунитета поствакцинального в мире, большое. И, конечно же, ситуация в целом в мире отражается у нас... В мире эта ситуация продолжается, но в Российской Федерации охваты высокие", - сказала Попова в интервью телеканалу "Россия 24".
Она уточнила, что вакцин в стране сегодня достаточно, национальный календарь прививок и по эпидпоказаниям выполняется, отречения от прививок нет.
"Коллеги очень активно работают - и коллеги в системе Роспотребнадзора, и в здравоохранении - с тем, чтобы выполнить свою работу и охваты были высокими. Они таковыми и являются. Сегодня по нашему календарю и дети, и взрослые защищены достаточно хорошо", - добавила Попова.